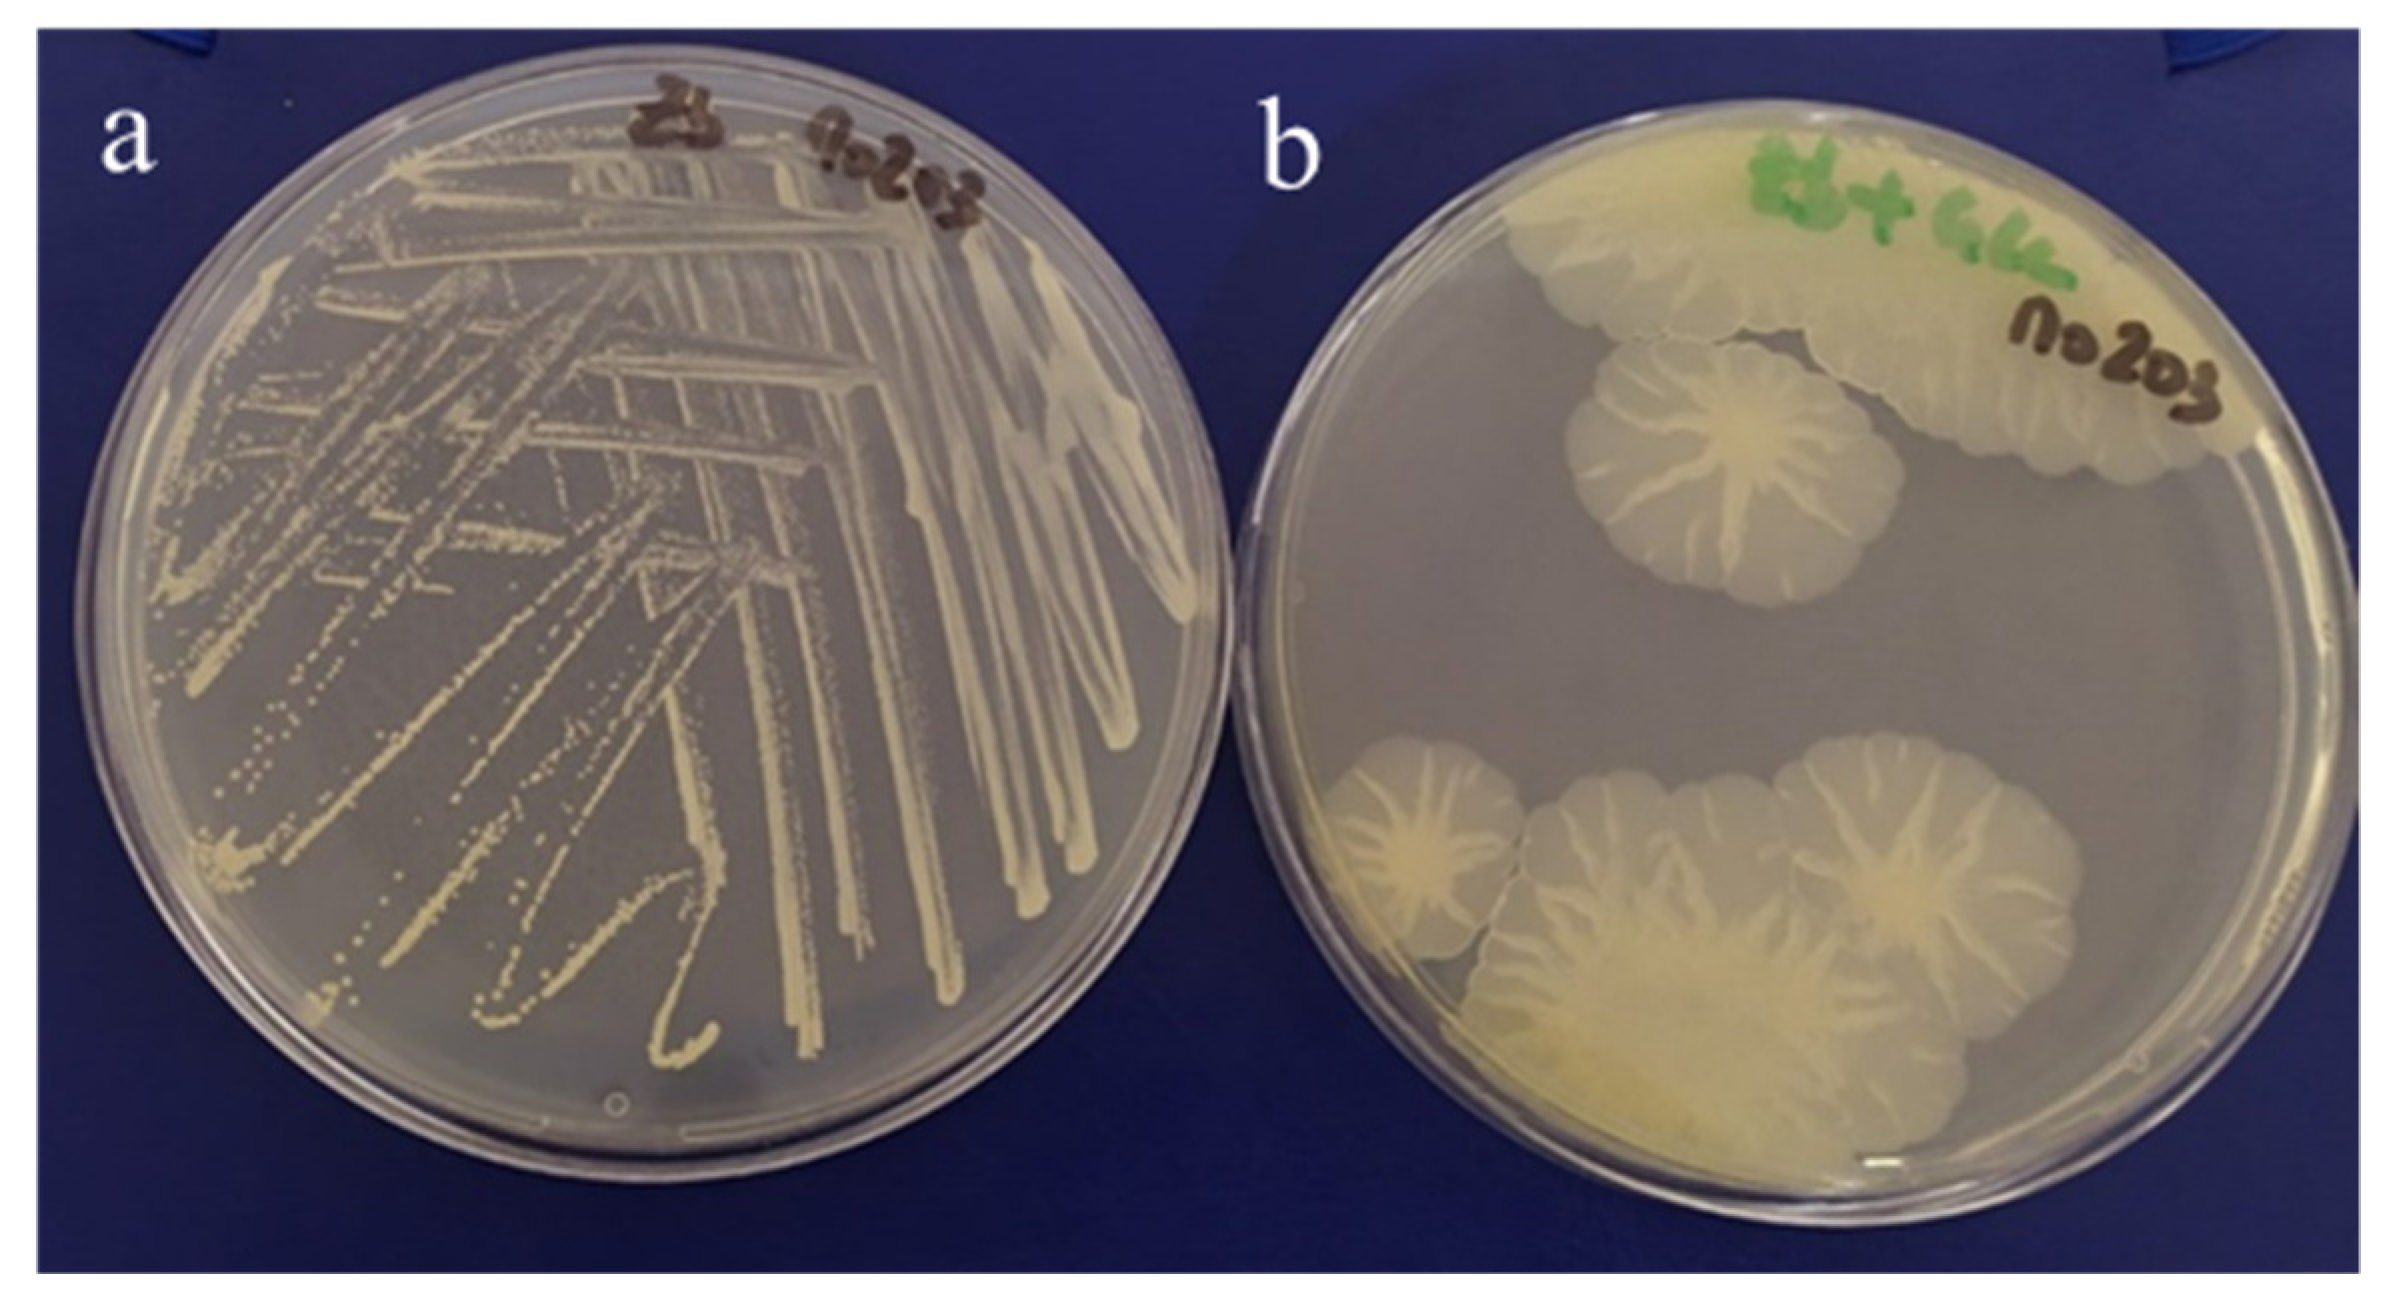
Marinedrugs 19 00522 g001

Characterization and Biotechnological Potential of Extracellular Polysaccharides Synthesized by Alteromonas Strains Isolated from French Polynesia Marine Environments
Abstract
:1. Introduction
2. Results and Discussion
2.1. Isolation and Identification of EPS Producing Strains
2.2. EPS Characterization
2.2.1. Chemical Composition
2.2.2. Fourier Transform Infra-Red (FTIR) Spectroscopy
2.2.3. Molecular Mass Distribution
2.2.4. Thermogravimetric Analysis
2.3. EPS Functional Properties
2.3.1. Rheological Properties
2.3.2. Gel Forming Capacity
3. Materials and Methods
3.1. Sample Collection and Bacterial Isolation
3.2. EPS Production and Extraction
3.3. EPS Characterization
3.3.1. EPS Composition
3.3.2. Fourier Transform Infra-Red (FTIR) Spectroscopy
3.3.3. Molecular Mass Distribution
3.3.4. Thermogravimetry (TG) Analysis
3.4. EPS Functional Properties
3.4.1. Rheological Properties
3.4.2. Gel Forming Capacity
4. Conclusions
Author Contributions
Funding
Institutional Review Board Statement
Informed Consent Statement
Data Availability Statement
Conflicts of Interest
Appendix A

Appendix B
| EPS | Temperature (°C) | Weight Loss (%) |
|---|---|---|
| A | 40.20–192.81 193.18–405.15 | 14.6 42.5 |
| B | 40.59–186.14 186.33–418.89 | 13.8 36.4 |
| C | 37.97–189.07 189.47–428.81 | 14.2 30.2 |
| D | 38.6–183.88 184.46–385.68 | 12.7 45.1 |
| E | 36.61–188.77 189.49–390.41 | 17.5 44.8 |
| F | 45.14–73.09 212.40–385.88 | 12.1 41.5 |
Appendix C

References
- Roca, C.; Lehmann, M.; Torres, C.A.V.; Baptista, S.; Gaudêncio, S.P.; Freitas, F.; Reis, M.A.M. Exopolysaccharide Production by a Marine Pseudoalteromonas Sp. Strain Isolated from Madeira Archipelago Ocean Sediments. New Biotechnol. 2016, 33, 460–466. [Google Scholar] [CrossRef] [PubMed]
- Casillo, A.; Lanzetta, R.; Parrilli, M.; Corsaro, M.M. Exopolysaccharides from Marine and Marine Extremophilic Bacteria: Structures, Properties, Ecological Roles and Applications. Mar. Drugs 2018, 16, 69. [Google Scholar] [CrossRef] [PubMed] [Green Version]
- Chalkiadakis, E.; Dufourcq, R.; Schmitt, S.; Brandily, C.; Kervarec, N.; Coatanea, D.; Amir, H.; Loubersac, L.; Chanteau, S.; Guezennec, J.; et al. Partial Characterization of an Exopolysaccharide Secreted by a Marine Bacterium, Vibrio Neocaledonicus Sp. Nov., from New Caledonia. J. Appl. Microbiol. 2013, 114, 1702–1712. [Google Scholar] [CrossRef] [PubMed] [Green Version]
- Martin-Pastor, M.; Ferreira, A.S.; Moppert, X.; Nunes, C.; Coimbra, M.A.; Reis, R.L.; Guezennec, J.; Novoa-Carballal, R. Structure, Rheology, and Copper-Complexation of a Hyaluronan-like Exopolysaccharide from Vibrio. Carbohydr. Polym. 2019, 222, 114999. [Google Scholar] [CrossRef]
- Guezennec, J. Deep-Sea Hydrothermal Vents: A New Source of Innovative Bacterial Exopolysaccharides of Biotechnological Interest? J. Ind. Microbiol. Biotechnol. 2002, 29, 204–208. [Google Scholar] [CrossRef]
- Delbarre-Ladrat, C.; Salas, M.L.; Sinquin, C.; Zykwinska, A.; Colliec-Jouault, S. Bioprospecting for Exopolysaccharides from Deep-Sea Hydrothermal Vent Bacteria: Relationship between Bacterial Diversity and Chemical Diversity. Microorganisms 2017, 5, 63. [Google Scholar] [CrossRef] [Green Version]
- Nichols, C.M.; Lardière, S.G.; Bowman, J.P.; Nichols, P.D.; Gibson, J.A.E.; Guézennec, J. Chemical Characterization of Exopolysaccharides from Antarctic Marine Bacteria. Microb. Ecol. 2005, 49, 578–589. [Google Scholar] [CrossRef]
- Donot, F.; Fontana, A.; Baccou, J.C.; Schorr-Galindo, S. Microbial Exopolysaccharides: Main Examples of Synthesis, Excretion, Genetics and Extraction. Carbohydr. Polym. 2012, 87, 951–962. [Google Scholar] [CrossRef]
- More, T.T.; Yadav, J.S.S.; Yan, S.; Tyagi, R.D.; Surampalli, R.Y. Extracellular Polymeric Substances of Bacteria and Their Potential Environmental Applications. J. Environ. Manag. 2014, 144, 1–25. [Google Scholar] [CrossRef]
- Wang, J.; Salem, D.R.; Sani, R.K. Extremophilic Exopolysaccharides: A Review and New Perspectives on Engineering Strategies and Applications. Carbohydr. Polym. 2019, 205, 8–26. [Google Scholar] [CrossRef]
- Zhang, Z.; Cai, R.; Zhang, W.; Fu, Y.; Jiao, N. A Novel Exopolysaccharide with Metal Adsorption Capacity Produced by a Marine Bacterium Alteromonas sp. JL2810. Mar. Drugs 2017, 15, 175. [Google Scholar] [CrossRef] [PubMed] [Green Version]
- Freitas, F.; Torres, C.A.V.; Reis, M.A.M. Engineering Aspects of Microbial Exopolysaccharide Production. Bioresour. Technol. 2017, 245, 1674–1683. [Google Scholar] [CrossRef] [PubMed]
- Sahana, T.G.; Rekha, P.D. A Bioactive Exopolysaccharide from Marine Bacteria Alteromonas sp. PRIM-28 and Its Role in Cell Proliferation and Wound Healing in Vitro. Int. J. Biol. Macromol. 2019, 131, 10–18. [Google Scholar] [CrossRef]
- Zarandona, I.; Estupiñán, M.; Pérez, C.; Alonso-Sáez, L.; Guerrero, P.; de la Caba, K. Chitosan Films Incorporated with Exopolysaccharides from Deep Seawater Alteromonas sp. Mar. Drugs 2020, 18, 447. [Google Scholar] [CrossRef]
- Nichols, C.A.M.; Guezennec, J.; Bowman, J.P. Bacterial Exopolysaccharides from Extreme Marine Environments with Special Consideration of the Southern Ocean, Sea Ice, and Deep-Sea Hydrothermal Vents: A Review. Mar. Biotechnol. 2005, 7, 253–271. [Google Scholar] [CrossRef] [PubMed] [Green Version]
- Guézennec, J.; Moppert, X.; Raguénès, G.; Richert, L.; Costa, B.; Simon-Colin, C. Microbial Mats in French Polynesia and Their Biotechnological Applications. Process. Biochem. 2011, 46, 16–22. [Google Scholar] [CrossRef] [Green Version]
- Zykwinska, A.; Berre, L.T.-L.; Sinquin, C.; Ropartz, D.; Rogniaux, H.; Colliec-Jouault, S.; Delbarre-Ladrat, C. Enzymatic Depolymerization of the GY785 Exopolysaccharide Produced by the Deep-Sea Hydrothermal Bacterium Alteromonas infernus: Structural Study and Enzyme Activity Assessment. Carbohydr. Polym. 2018, 188, 101–107. [Google Scholar] [CrossRef] [Green Version]
- Loaëc, M.; Olier, R.; Guezennec, J. Chelating Properties of Bacterial Exopolysaccharides from Deep-Sea Hydrothermal Vents. Carbohydr. Polym. 1998, 35, 65–70. [Google Scholar] [CrossRef]
- Mata, J.A.; Bjar, V.; Bressollier, P.; Tallon, R.; Urdaci, M.C.; Quesada, E.; Llamas, I. Characterization of Exopolysaccharides Produced by Three Moderately Halophilic Bacteria Belonging to the Family Alteromonadaceae. J. Appl. Microbiol. 2008, 105, 521–528. [Google Scholar] [CrossRef]
- Torres, M.; Hong, K.-W.; Chong, T.-M.; Reina, J.C.; Chan, K.-G.; Dessaux, Y.; Llamas, I. Genomic Analyses of Two Alteromonas stellipolaris Strains Reveal Traits with Potential Biotechnological Applications. Sci. Rep. 2019, 9, 1–14. [Google Scholar] [CrossRef] [Green Version]
- Le Costaouëc, T.; Cérantola, S.; Ropartz, D.; Ratiskol, J.; Sinquin, C.; Colliec-Jouault, S.; Boisset, C. Structural Data on a Bacterial Exopolysaccharide Produced by a Deep-Sea Alteromonas macleodii Strain. Carbohydr. Polym. 2012, 90, 49–59. [Google Scholar] [CrossRef] [Green Version]
- Roca, C.; Alves, V.D.; Freitas, F.; Reis, M.A.M. Exopolysaccharides Enriched in Rare Sugars: Bacterial Sources, Production, and Applications. Front. Microbiol. 2015, 6, 288. [Google Scholar] [CrossRef]
- de Jesus Raposo, M.; de Morais, A.; de Morais, R. Marine Polysaccharides from Algae with Potential Biomedical Applications. Mar. Drugs 2015, 13, 2967–3028. [Google Scholar] [CrossRef]
- Liu, L.; Pohnert, G.; Wei, D. Extracellular Metabolites from Industrial Microalgae and Their Biotechnological Potential. Mar. Drugs 2016, 14, 191. [Google Scholar] [CrossRef] [PubMed]
- Xiao, R.; Zheng, Y. Overview of Microalgal Extracellular Polymeric Substances (EPS) and Their Applications. Biotechnol. Adv. 2016, 34, 1225–1244. [Google Scholar] [CrossRef]
- Singh, S.; Kant, C.; Yadav, R.K.; Reddy, Y.P.; Abraham, G. Cyanobacterial Exopolysaccharides: Composition, Biosynthesis, and Biotechnological Applications. In Cyanobacteria; Elsevier: London, UK, 2019; pp. 347–358. ISBN 978-0-12-814667-5. [Google Scholar]
- Raguénès, G.; Cambon-Bonavita, M.A.; Lohier, J.F.; Boisset, C.; Guezennec, J. A Novel, Highly Viscous Polysaccharide Excreted by an Alteromonas Isolated from a Deep-Sea Hydrothermal Vent Shrimp. Curr. Microbiol. 2003, 46, 448–452. [Google Scholar] [CrossRef] [PubMed]
- Concórdio-Reis, P.; Pereira, C.V.; Batista, M.P.; Sevrin, C.; Grandfils, C.; Marques, A.C.; Fortunato, E.; Gaspar, F.B.; Matias, A.A.; Freitas, F.; et al. Silver Nanocomposites Based on the Bacterial Fucose-Rich Polysaccharide Secreted by Enterobacter A47 for Wound Dressing Applications: Synthesis, Characterization and in Vitro Bioactivity. Int. J. Biol. Macromol. 2020, 163, 959–969. [Google Scholar] [CrossRef] [PubMed]
- Chen, X.; Song, L.; Wang, H.; Liu, S.; Yu, H.; Wang, X.; Li, R.; Liu, T.; Li, P. Partial Characterization, the Immune Modulation and Anticancer Activities of Sulfated Polysaccharides from Filamentous Microalgae Tribonema sp. Molecules 2019, 24, 322. [Google Scholar] [CrossRef] [Green Version]
- Liu, X.; Zhang, M.; Liu, H.; Zhou, A.; Cao, Y.; Liu, X. Preliminary Characterization of the Structure and Immunostimulatory and Anti-Aging Properties of the Polysaccharide Fraction of Haematococcus pluvialis. RSC Adv. 2018, 8, 9243–9252. [Google Scholar] [CrossRef] [Green Version]
- Trabelsi, L.; Chaieb, O.; Mnari, A.; Abid-Essafi, S.; Aleya, L. Partial Characterization and Antioxidant and Antiproliferative Activities of the Aqueous Extracellular Polysaccharides from the Thermophilic Microalgae Graesiella sp. BMC Complement. Altern. Med. 2016, 16, 1–10. [Google Scholar] [CrossRef]
- Insulkar, P.; Kerkar, S.; Lele, S.S. Purification and Structural-Functional Characterization of an Exopolysaccharide from Bacillus licheniformis PASS26 with in-Vitro Antitumor and Wound Healing Activities. Int. J. Biol. Macromol. 2018, 120, 1441–1450. [Google Scholar] [CrossRef]
- Rütering, M.; Schmid, J.; Gansbiller, M.; Braun, A.; Kleinen, J.; Schilling, M.; Sieber, V. Rheological Characterization of the Exopolysaccharide Paenan in Surfactant Systems. Carbohydr. Polym. 2018, 181, 719–726. [Google Scholar] [CrossRef]
- Ji, S.; Li, H.; Wang, G.; Lu, T.; Ma, W.; Wang, J.; Zhu, H.; Xu, H. Rheological Behaviors of a Novel Exopolysaccharide Produced by Sphingomonas WG and the Potential Application in Enhanced Oil Recovery. Int. J. Biol. Macromol. 2020, 162, 1816–1824. [Google Scholar] [CrossRef]
- Cruz, M.; Freitas, F.; Torres, C.A.V.; Reis, M.A.M.; Alves, V.D. Influence of Temperature on the Rheological Behavior of a New Fucose-Containing Bacterial Exopolysaccharide. Int. J. Biol. Macromol. 2011, 48, 695–699. [Google Scholar] [CrossRef]
- Alves, V.D.; Freitas, F.; Costa, N.; Carvalheira, M.; Oliveira, R.; Gonçalves, M.P.; Reis, M.A.M. Effect of Temperature on the Dynamic and Steady-Shear Rheology of a New Microbial Extracellular Polysaccharide Produced from Glycerol Byproduct. Carbohydr. Polym. 2010, 79, 981–988. [Google Scholar] [CrossRef]
- Freitas, F.; Alves, V.D.; Torres, C.A.V.; Cruz, M.; Sousa, I.; Melo, M.J.; Ramos, A.M.; Reis, M.A.M. Fucose-Containing Exopolysaccharide Produced by the Newly Isolated Enterobacter Strain A47 DSM 23139. Carbohydr. Polym. 2011, 83, 159–165. [Google Scholar] [CrossRef] [Green Version]
- Carreau, P.J. Rheological Equations from Molecular Network Theories. J. Rheol. 1972, 16, 99–127. [Google Scholar] [CrossRef]
- Torres, C.A.V.; Ferreira, A.R.V.; Freitas, F.; Reis, M.A.M.; Coelhoso, I.; Sousa, I.; Alves, V.D. Rheological Studies of the Fucose-Rich Exopolysaccharide FucoPol. Int. J. Biol. Macromol. 2015, 79, 611–617. [Google Scholar] [CrossRef] [PubMed]
- Hu, H.; Xu, F.-J. Rational Design and Latest Advances of Polysaccharide-Based Hydrogels for Wound Healing. Biomater. Sci. 2020, 8, 2084–2101. [Google Scholar] [CrossRef]
- Zykwinska, A.; Marquis, M.; Sinquin, C.; Cuenot, S.; Colliec-Jouault, S. Assembly of HE800 Exopolysaccharide Produced by a Deep-Sea Hydrothermal Bacterium into Microgels for Protein Delivery Applications. Carbohydr. Polym. 2016, 142, 213–221. [Google Scholar] [CrossRef] [PubMed] [Green Version]
- Hoppe, A.; Güldal, N.S.; Boccaccini, A.R. A Review of the Biological Response to Ionic Dissolution Products from Bioactive Glasses and Glass-Ceramics. Biomaterials 2011, 32, 2757–2774. [Google Scholar] [CrossRef]
- Zobell, C.E. Studies on Marine Bacteria. I. The Cultural Requirements of Heterotrophic Aerobes. J. Mar. Res. 1941, 4, 42–75. [Google Scholar]
- Oppenheimer, C.H.; Zobell, C.E. The Growth and Viability of Sixty-Three Species of Marine Bacteria as Influenced by Hydrostatic Pressure. J. Mar. Res. 1952, 11, 10–18. [Google Scholar]
- Raguenes, G.; Pignet, P.; Gauthier, G.; Peres, A.; Christen, R.; Rougeaux, H.; Barbier, G.; Guezennec, J. Description of a New Polymer-Secreting Bacterium from a Deep-Sea Hydrothermal Vent, Alteromonas macleodii Subsp. fijiensis, and Preliminary Characterization of the Polymer. Appl. Environ. Microbiol. 1996, 62, 67–73. [Google Scholar] [CrossRef] [PubMed] [Green Version]
- Cambon-Bonavita, M.-A.; Raguenes, G.; Jean, J.; Vincent, P.; Guezennec, J. A Novel Polymer Produced by a Bacterium Isolated from a Deep-Sea Hydrothermal Vent Polychaete Annelid. J. Appl. Microbiol. 2002, 93, 310–315. [Google Scholar] [CrossRef]
- Tilmans, J.; Philippi, J. Uber Den Gehalt Der Wichtigsten Protein Der Nahrangsmittel an Kohlehydrat Andu¨ber Ein Kolorimetriches Verfharen Zur Quantitativen Beshimmung von Stucksoffreiem Zucker in Elweiss. Biochim. Ztg. 1929, 215, 36–60. [Google Scholar]
- Rimington, C. The Carbohydrate Complex of Serum Protein II: Improved Method for Isolation and Determination of Structure. Isolation of Glucosaminodimannose from Protein of Blood. Biochem. J. 1931, 25, 1062–1071. [Google Scholar] [CrossRef] [PubMed] [Green Version]
- Blumenkrantz, N.; Asboe-Hansen, G. New Method for Quantitative Determination of Uronic Acid. Anal. Biochem. 1973, 54, 484–489. [Google Scholar] [CrossRef]
- Kamerling, J.P.; Gerwig, G.J.; Vliegenhart, J.F.G.; Clamp, J.R. Characterization by Gas Chromatography-Mass Spectrometry of Pertrimethylsilyl Glycosides Obtained in the Methanolysis of Glycoproteins and Glycolipids. Biochem. J. 1975, 151, 491–495. [Google Scholar] [CrossRef] [Green Version]
- Montreuil, J.; Bouquelet, S.; Debray, H.; Fournet, B.; Spik, G.; Strecker, G. Glycoproteins. In Carbohydrate Analysis: A Practical Approach; IRL Press: Washington, DC, USA, 1986; pp. 143–204. [Google Scholar]
- Concórdio-Reis, P.; Reis, M.A.M.; Freitas, F. Biosorption of Heavy Metals by the Bacterial Exopolysaccharide FucoPol. Appl. Sci. 2020, 10, 6708. [Google Scholar] [CrossRef]
- Shimada, A.; Nakata, H.; Nakamura, I. Acidic Exopolysaccharide Produced by Enterobacter sp. J. Ferment. Bioeng. 1997, 84, 113–118. [Google Scholar] [CrossRef]

| EPS | Isolate Strain Designation | Sampling Site | Sample Source | Accession Number |
|---|---|---|---|---|
| A | Mo 169 | Moorea Island lagoon | Giant clam (Tridacna maxima) | CNCM I-5374 |
| B | Mo 278 | Moorea Island lagoon | Sea Anemone (Actiniaria) | CNCM I-5375 |
| C | Fak 1576 | Fakarava atoll | Coral | CNCM I-5376 |
| D | Tik 650 | Tikehau atoll | “Kopara” mat | CNCM I-5523 |
| E | Fak 1386 | Fakarava atoll | Pearl oyster mantle | CNCM I-5524 |
| F | Mo 203 | Moorea Island lagoon | “Kopara” mat | CNCM I-3970 |
| EPS | Monosaccharide Composition (Molar Ratio) | Acyl Groups (wt%) | Sulfate (wt%) | Protein (wt%) | Inorganic Content (wt%) | Mw (MDa) | PDI | Tdeg (°C) |
|---|---|---|---|---|---|---|---|---|
| A | Glc:GlcA:Man:Gal:GalA (2.5:2.5:1.5:1.5:1.5) | Ac (0.5 ± 0.1) Pyr (4.9 ± 0.1) | 2.8 ± 0.1 | 2.8 ± 0.4 | 7.7 ± 1.5 | 1.6 4.6 1 | 1.3 1.3 1 | 269 |
| B | Gal:GlcA:Glc:GalA (2:1.5:1:1) | Ac (0.5 ± 0.0) Pyr (0.2 ± 0.0) Suc (1.8 ± 0.1) | 3.3 ± 0.3 | 3.5 ± 0.1 | 20.0 ± 1.7 | 4.6 | 1.4 | 265 |
| C | Gal:Rha:Man:Glc:GlcA:GalA:Fuc (4.5:2:1.5:1:1:1:0.5) | Pyr (1.1 ± 0.2) | 3.4 ±0.0 | 2.6 ± 1.0 | 34.7 ± 0.2 | 1.2 | 1.4 | 268 |
| D | GlcA:Glc:Gal:Man:GalA (3:2:2:1.5:1.5) | Ac (2.1 ± 0.0) | 2.0 ± 0.0 | 6.8 ± 0.2 | 11.4 ± 0.3 | 1.4 | 1.5 | 262 |
| E | Gal:Man:Rha:Glc:GlcA:GalA (3:2:1:1:1:1) | Suc (1.0 ± 0.0) | 2.9 ± 0.0 | 2.1 ± 0.3 | 15.0 ± 0.1 | 2.5 4.3 1 | 1.1 1.5 1 | 267 |
| F | Glc:Gal:GlcA:Rha:GalA (2:2:2:1:1) | Ac (0.7 ± 0.0) Pyr (5.5 ± 0.3) | 3.4 ± 0.0 | 1.7 ± 0.0 | 13.7 ± 0.3 | 3.2 | 1.2 | 260 |
| EPS | η0 (Pa.s) | n (−) | λ (s) | r2 | MRE * (%) |
|---|---|---|---|---|---|
| A | 76.2 ± 2.1 | 0.181 ± 0.051 | 24.6 ± 2.8 | 0.999 | 13.6 |
| B | 16.1 ± 0.3 | 0.361 ± 0.024 | 19.7 ± 1.5 | 0.999 | 9.8 |
| C | 11.3 ± 0.2 | 0.437 ± 0.021 | 17.7 ± 1.5 | 0.999 | 14.9 |
| D | 0.74 ± 0.02 | 0.549 ± 0.034 | 2.26 ± 0.27 | 0.998 | 5.6 |
| E | 26.3 ± 0.4 | 0.338 ± 0.025 | 21.2 ± 1.6 | 0.999 | 5.9 |
| F | 0.09 ± 0.01 | 0.772 ± 0.056 | 0.07 ± 0.04 | 0.998 | 3.1 |
| Standard Conditions | ||||||
|---|---|---|---|---|---|---|
| Cation | A | B | C | D | E | F |
| Mg2+ | ||||||
| Cu2+ | - | - | -- | |||
| Ca2+ | ||||||
| Fe2+ | + | + | ||||
| Fe3+ | - | -- | - | |||
| Alkaline conditions | ||||||
| Cation | A | B | C | D | E | F |
| Mg2+ | + | - | - | -- | - | + |
| Cu2+ | + | -- | -- | |||
| Ca2+ | + | - | -- | -- | + | |
| Fe2+ | - | - | -- | -- | -- | - |
| Fe3+ | -- | -- | -- | -- | ||
Publisher’s Note: MDPI stays neutral with regard to jurisdictional claims in published maps and institutional affiliations. |
© 2021 by the authors. Licensee MDPI, Basel, Switzerland. This article is an open access article distributed under the terms and conditions of the Creative Commons Attribution (CC BY) license (https://creativecommons.org/licenses/by/4.0/).
Share and Cite
Concórdio-Reis, P.; Alves, V.D.; Moppert, X.; Guézennec, J.; Freitas, F.; Reis, M.A.M. Characterization and Biotechnological Potential of Extracellular Polysaccharides Synthesized by Alteromonas Strains Isolated from French Polynesia Marine Environments. Mar. Drugs 2021, 19, 522. https://doi.org/10.3390/md19090522
Concórdio-Reis P, Alves VD, Moppert X, Guézennec J, Freitas F, Reis MAM. Characterization and Biotechnological Potential of Extracellular Polysaccharides Synthesized by Alteromonas Strains Isolated from French Polynesia Marine Environments. Marine Drugs. 2021; 19(9):522. https://doi.org/10.3390/md19090522
Chicago/Turabian StyleConcórdio-Reis, Patrícia, Vítor D. Alves, Xavier Moppert, Jean Guézennec, Filomena Freitas, and Maria A. M. Reis. 2021. "Characterization and Biotechnological Potential of Extracellular Polysaccharides Synthesized by Alteromonas Strains Isolated from French Polynesia Marine Environments" Marine Drugs 19, no. 9: 522. https://doi.org/10.3390/md19090522
APA StyleConcórdio-Reis, P., Alves, V. D., Moppert, X., Guézennec, J., Freitas, F., & Reis, M. A. M. (2021). Characterization and Biotechnological Potential of Extracellular Polysaccharides Synthesized by Alteromonas Strains Isolated from French Polynesia Marine Environments. Marine Drugs, 19(9), 522. https://doi.org/10.3390/md19090522

